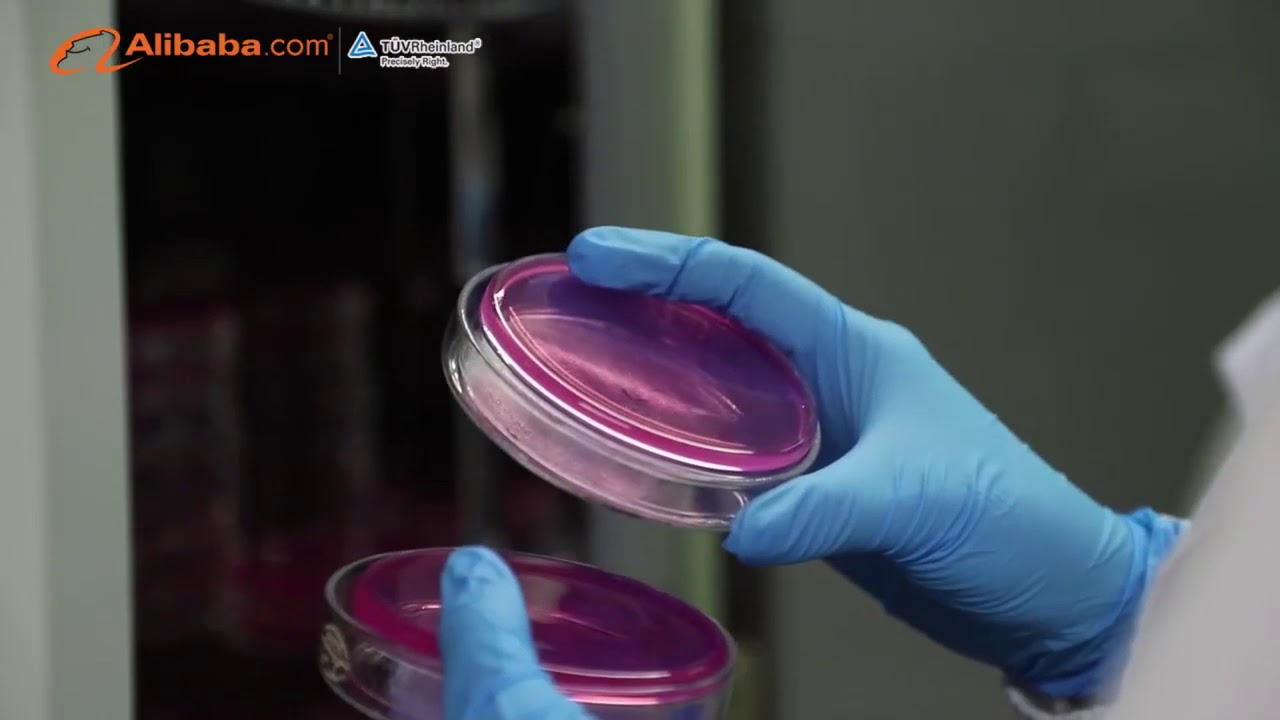

Guangdong Yichao Biological is a leading gummy vitamin manufacturer. To view a wide variety of pectin gummy traders sold by certified suppliers, manufacturers and wholesalers, visit
Guangdong yi town boat technology company limited founded in two thousand five, is a design and development production cells in one of coming. Vitamin packed gummy probiotic gummy soft gels and tablets. Production and trading company.
This gummy vitamin manufacturer has a rich experience in softgels manufacturer,protein granules,nutrition tablets supplier. Check out for a range of pectin gummy at Alibaba:
The company is located in the hometown of passion entrepreneurship shantou city day superior geographical location, convenient transportation. The company has an area of thirty five thousand square meters of modern plant and office space. Our products gain wide praises at home and abroad.$$$$Our company has one c q iso twenty two thousand et cetera independent design development, production of products sold around the world. Have our customers, we have a group of experienced developers and experienced staff will be ready to discuss your needs with you.$$$$We can do oem and oem whether you are selecting a current product from our catalogue was seeking engineering help for your application. We can also conduct food testing, according to customer requirements. Our production line can guarantee a steady rate of twenty five hundred kilograms per hour.$$$$ Strict production management process enables our products from raw material procurement to packaging every step of the process can be controlled. Our mission is to become a world class health through development and manufacturing expert strive to implement the company’s core values study operation standard, the management science and technology.$$$$First, rigorous and pragmatic on the basis of long term mutual benefit and reciprocity. The company warmly welcome customers at home and abroad to establish cooperative relations with us for common development and a better future.
To more about Guangdong Yichao Biological, visit